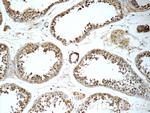
TSNAXIP1 Antibody in Immunohistochemistry (Paraffin) (IHC (P))

Search
Proteintech
TSNAXIP1 Polyclonal Antibody
{{$productOrderCtrl.translations['antibody.pdp.commerceCard.promotion.promotions']}}
{{$productOrderCtrl.translations['antibody.pdp.commerceCard.promotion.viewpromo']}}
{{$productOrderCtrl.translations['antibody.pdp.commerceCard.promotion.promocode']}}: {{promo.promoCode}} {{promo.promoTitle}} {{promo.promoDescription}}. {{$productOrderCtrl.translations['antibody.pdp.commerceCard.promotion.learnmore']}}
产品信息
17730-1-AP
种属反应
宿主/亚型
分类
类型
抗原
偶联物
形式
浓度
规格
纯化类型
保存液
内含物
保存条件
运输条件
产品详细信息
Immunogen sequence: SELQEIQRT STPRPDWTKC KDVVAGGPER WQMLAEGKNS DQLVDVLLEE IGSGLLREKD FFPGLGYGEA IPAFLRFDGL VENKKPSKKD VVNLLKDAWK ERLAEEQKET FPDFFFNFLE HRFGPSDAMA WAYTIFENIK IFHSNEVMSQ FYAVLMGKRS ENVYVTQKET VAQLLKEMTN ADSQNEGLLT MEQFNTVLKS TFPLKTEEQI QELMEAGGWH PSSSNADLLN YRSLFMEDEE GQSEPFVQKL WEQYMDEKDE YLQQLKQELG IELHEEVTLP KLRGGLMTID PSLDKQTVNT YMSQAFQLPE SEMPEEGDEK EEAVVEILQT ALERLQVIDI RRVGPREPEP AS (308-658 aa encoded by BC111018)
靶标信息
Possible role in spermatogenesis.
仅用于科研。不用于诊断过程。未经明确授权不得转售。
生物信息学
蛋白别名: OR1; Translin-associated factor X-interacting protein 1; Trax-interacting protein 1; tsnaxip1; unnamed protein product
基因别名: 1700016K08Rik; TSNAXIP1; TXI1
UniProt ID: (Human) Q2TAA8, (Mouse) Q99P25
Entrez Gene ID: (Human) 55815, (Mouse) 72236